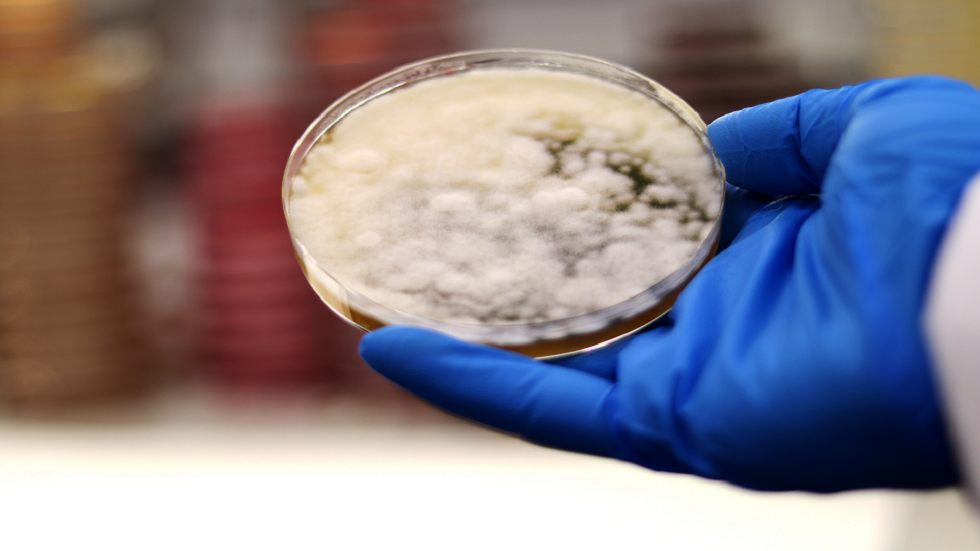

Stories
-
![مونديال 2026]()
مونديال 2026
RT STORIES
إنجلترا تتصدر المجموعة الـ12 بثنائية في بنما في ليلة تاريخية لكين بمونديال 2026
![إنجلترا تتصدر المجموعة الـ12 بثنائية في بنما في ليلة تاريخية لكين بمونديال 2026]() #اسأل_أكثر #Question_More
#اسأل_أكثر #Question_MoreRT STORIES
"سرقوا حلم أمة".. إبراهيموفيتش يشن هجوما حادا على حكام "VAR" بعد دراما مباراة مصر وإيران
!["سرقوا حلم أمة".. إبراهيموفيتش يشن هجوما حادا على حكام "VAR" بعد دراما مباراة مصر وإيران]() #اسأل_أكثر #Question_More
#اسأل_أكثر #Question_MoreRT STORIES
حسابات معقدة.. كيف تتأهل إيران إلى دور الـ32 لكأس العالم؟
![حسابات معقدة.. كيف تتأهل إيران إلى دور الـ32 لكأس العالم؟]() #اسأل_أكثر #Question_More
#اسأل_أكثر #Question_MoreRT STORIES
مصر تفتح صفحة جديدة في كأس العالم بأرقام لم تحققها من قبل
![مصر تفتح صفحة جديدة في كأس العالم بأرقام لم تحققها من قبل]() #اسأل_أكثر #Question_More
#اسأل_أكثر #Question_MoreRT STORIES
بعد تألقه في كأس العالم.. الهلال السعودي يسارع الخطى نحو محمد صلاح (فيديو)
![بعد تألقه في كأس العالم.. الهلال السعودي يسارع الخطى نحو محمد صلاح (فيديو)]() #اسأل_أكثر #Question_More
#اسأل_أكثر #Question_MoreRT STORIES
رد فعل زيزو بعد انتقادات أبو تريكة (فيديو)
![رد فعل زيزو بعد انتقادات أبو تريكة (فيديو)]() #اسأل_أكثر #Question_More
#اسأل_أكثر #Question_MoreRT STORIES
أول قرار لأشرف حكيمي بعد تأييد إحالته إلى المحاكمة في فرنسا
![أول قرار لأشرف حكيمي بعد تأييد إحالته إلى المحاكمة في فرنسا]() #اسأل_أكثر #Question_More
#اسأل_أكثر #Question_MoreRT STORIES
لماذا ألغى الحكم هدف إيران الثاني في شباك مصر؟
![لماذا ألغى الحكم هدف إيران الثاني في شباك مصر؟]() #اسأل_أكثر #Question_More
#اسأل_أكثر #Question_MoreRT STORIES
كم تبلغ مكافأة منتخب مصر بعد تأهله إلى دور الـ 32 في كأس العالم؟
![كم تبلغ مكافأة منتخب مصر بعد تأهله إلى دور الـ 32 في كأس العالم؟]() #اسأل_أكثر #Question_More
#اسأل_أكثر #Question_MoreRT STORIES
"الشرف قبل النصر".. منتخب إيران يترك رسالة مؤثرة في غرفة تبديل الملابس بعد التعادل مع مصر
!["الشرف قبل النصر".. منتخب إيران يترك رسالة مؤثرة في غرفة تبديل الملابس بعد التعادل مع مصر]() #اسأل_أكثر #Question_More
#اسأل_أكثر #Question_MoreRT STORIES
أزمة قوية تضرب منتخب أستراليا قبل لقاء مصر في دور 32 من كأس العالم
![أزمة قوية تضرب منتخب أستراليا قبل لقاء مصر في دور 32 من كأس العالم]() #اسأل_أكثر #Question_More
#اسأل_أكثر #Question_MoreRT STORIES
أول تعليق من حسام حسن بعد تعادل مصر مع إيران وتأهلها لدور الـ32 في كأس العالم
![أول تعليق من حسام حسن بعد تعادل مصر مع إيران وتأهلها لدور الـ32 في كأس العالم]() #اسأل_أكثر #Question_More
#اسأل_أكثر #Question_MoreRT STORIES
أبو تريكة يفاجئ مصطفى شوبير على الهواء بعد مباراة مصر وإيران
![أبو تريكة يفاجئ مصطفى شوبير على الهواء بعد مباراة مصر وإيران]() #اسأل_أكثر #Question_More
#اسأل_أكثر #Question_MoreRT STORIES
أول تعليق من دونيس بعد خروج المنتخب السعودي من كأس العالم 2026
![أول تعليق من دونيس بعد خروج المنتخب السعودي من كأس العالم 2026]() #اسأل_أكثر #Question_More
#اسأل_أكثر #Question_MoreRT STORIES
مدرب الأرجنتين يكشف موقف ميسي من المشاركة في مباراة الأردن
![مدرب الأرجنتين يكشف موقف ميسي من المشاركة في مباراة الأردن]() #اسأل_أكثر #Question_More
#اسأل_أكثر #Question_MoreRT STORIES
الموعد والقنوات الناقلة لمباراة الجزائر والنمسا اليوم في كأس العالم
![الموعد والقنوات الناقلة لمباراة الجزائر والنمسا اليوم في كأس العالم]() #اسأل_أكثر #Question_More
#اسأل_أكثر #Question_MoreRT STORIES
لقطة عفوية بين حسام حسن وإمام عاشور في مباراة مصر وإيران تكتسح الإنترنت (فيديو)
![لقطة عفوية بين حسام حسن وإمام عاشور في مباراة مصر وإيران تكتسح الإنترنت (فيديو)]() #اسأل_أكثر #Question_More
#اسأل_أكثر #Question_MoreRT STORIES
مدرب المنتخب الإيراني يعلق على تعادل بطعم الخسارة أمام مصر
![مدرب المنتخب الإيراني يعلق على تعادل بطعم الخسارة أمام مصر]() #اسأل_أكثر #Question_More
#اسأل_أكثر #Question_MoreRT STORIES
الكشف عن مستجدات داخل معسكر منتخب مصر قبل مواجهة أستراليا في دور الـ32 من مونديال 2026
![الكشف عن مستجدات داخل معسكر منتخب مصر قبل مواجهة أستراليا في دور الـ32 من مونديال 2026]() #اسأل_أكثر #Question_More
#اسأل_أكثر #Question_MoreRT STORIES
الإصابات تضرب منتخب مصر رغم التأهل إلى دور الـ32 في كأس العالم 2026
![الإصابات تضرب منتخب مصر رغم التأهل إلى دور الـ32 في كأس العالم 2026]() #اسأل_أكثر #Question_More
#اسأل_أكثر #Question_MoreRT STORIES
خريطة دور الـ32 تكتمل تدريجيا.. 28 منتخبا يتأهلون و9 مواجهات مؤكدة
![خريطة دور الـ32 تكتمل تدريجيا.. 28 منتخبا يتأهلون و9 مواجهات مؤكدة]() #اسأل_أكثر #Question_More
#اسأل_أكثر #Question_MoreRT STORIES
بلجيكا تمطر شباك نيوزيلندا بخماسية في كأس العالم 2026
![بلجيكا تمطر شباك نيوزيلندا بخماسية في كأس العالم 2026]() #اسأل_أكثر #Question_More
#اسأل_أكثر #Question_MoreRT STORIES
مصر تحسم التأهل إلى دور الـ32 رسميا بعد تعادل مثير مع إيران
![مصر تحسم التأهل إلى دور الـ32 رسميا بعد تعادل مثير مع إيران]() #اسأل_أكثر #Question_More
#اسأل_أكثر #Question_MoreRT STORIES
بهدف وحيد.. إسبانيا تحسم التأهل إلى دور الـ32 بعد فوز صعب على أوروغواي
![بهدف وحيد.. إسبانيا تحسم التأهل إلى دور الـ32 بعد فوز صعب على أوروغواي]() #اسأل_أكثر #Question_More
#اسأل_أكثر #Question_MoreRT STORIES
السعودية تودّع المونديال.. الرأس الأخضر يكتب التاريخ ويتأهل لدور الـ32
![السعودية تودّع المونديال.. الرأس الأخضر يكتب التاريخ ويتأهل لدور الـ32]() #اسأل_أكثر #Question_More
#اسأل_أكثر #Question_More![مونديال 2026]() مونديال 2026
مونديال 2026
-
![إسرائيل ولبنان يتوصلان إلى اتفاق إطار]()
إسرائيل ولبنان يتوصلان إلى اتفاق إطار
RT STORIES
بعد "الاتفاق الإطاري" مع لبنان.. نتنياهو يعرض المناطق التي ستبدأ فيها المرحلة التجريبية (صورة)
![بعد "الاتفاق الإطاري" مع لبنان.. نتنياهو يعرض المناطق التي ستبدأ فيها المرحلة التجريبية (صورة)]() #اسأل_أكثر #Question_More
#اسأل_أكثر #Question_MoreRT STORIES
"هآرتس": بنود "الاتفاق الإطار" الموقع في واشنطن تمهد الطريق لتحويل جنوب لبنان إلى "غزة 2"
!["هآرتس": بنود "الاتفاق الإطار" الموقع في واشنطن تمهد الطريق لتحويل جنوب لبنان إلى "غزة 2"]() #اسأل_أكثر #Question_More
#اسأل_أكثر #Question_MoreRT STORIES
وليد جنبلاط يرصد "أمرا غريبا" في الاتفاق بين لبنان وإسرائيل: "المربع الأسود"
![وليد جنبلاط يرصد "أمرا غريبا" في الاتفاق بين لبنان وإسرائيل: "المربع الأسود"]() #اسأل_أكثر #Question_More
#اسأل_أكثر #Question_MoreRT STORIES
هيئة علماء بيروت تحذر السلطات اللبنانية من خيار قاتل بعد توقيعها اتفاق الإطار مع إسرائيل
![هيئة علماء بيروت تحذر السلطات اللبنانية من خيار قاتل بعد توقيعها اتفاق الإطار مع إسرائيل]() #اسأل_أكثر #Question_More
#اسأل_أكثر #Question_MoreRT STORIES
قاسم: "اتفاق الإطار" بين بيروت وإسرائيل مذلة وعار
![قاسم: "اتفاق الإطار" بين بيروت وإسرائيل مذلة وعار]() #اسأل_أكثر #Question_More
#اسأل_أكثر #Question_MoreRT STORIES
لبنان.. إجراءات أمنية مشددة وعاجلة لمنع الشغب والإخلال بالأمن
![لبنان.. إجراءات أمنية مشددة وعاجلة لمنع الشغب والإخلال بالأمن]() #اسأل_أكثر #Question_More
#اسأل_أكثر #Question_MoreRT STORIES
محللون إسرائيليون: تل أبيب تدفع بلبنان نحو حرب أهلية
![محللون إسرائيليون: تل أبيب تدفع بلبنان نحو حرب أهلية]() #اسأل_أكثر #Question_More
#اسأل_أكثر #Question_MoreRT STORIES
رئيس البرلمان اللبناني نبيه بري يحذر اللبنانيين من الفتنة
![رئيس البرلمان اللبناني نبيه بري يحذر اللبنانيين من الفتنة]() #اسأل_أكثر #Question_More
#اسأل_أكثر #Question_MoreRT STORIES
الإذاعة الإسرائيلية: نتنياهو يؤكد أن الانسحاب من لبنان لن يتم إلا بعد نزع سلاح "حزب الله"
![الإذاعة الإسرائيلية: نتنياهو يؤكد أن الانسحاب من لبنان لن يتم إلا بعد نزع سلاح "حزب الله"]() #اسأل_أكثر #Question_More
#اسأل_أكثر #Question_MoreRT STORIES
الخارجية الأمريكية تنشر نص "اتفاق الإطار" بين لبنان وإسرائيل
![الخارجية الأمريكية تنشر نص "اتفاق الإطار" بين لبنان وإسرائيل]() #اسأل_أكثر #Question_More
#اسأل_أكثر #Question_MoreRT STORIES
سفير إسرائيل في واشنطن: إيران وحزب الله باتا خارج اللعبة
![سفير إسرائيل في واشنطن: إيران وحزب الله باتا خارج اللعبة]() #اسأل_أكثر #Question_More
#اسأل_أكثر #Question_MoreRT STORIES
لبنان وإسرائيل يوقعان "اتفاقا إطاريا ثلاثيا" برعاية أمريكية
![لبنان وإسرائيل يوقعان "اتفاقا إطاريا ثلاثيا" برعاية أمريكية]() #اسأل_أكثر #Question_More
#اسأل_أكثر #Question_More![إسرائيل ولبنان يتوصلان إلى اتفاق إطار]() إسرائيل ولبنان يتوصلان إلى اتفاق إطار
إسرائيل ولبنان يتوصلان إلى اتفاق إطار
-
![اتفاق أمريكي إيراني لوقف الحرب على جميع الجبهات]()
اتفاق أمريكي إيراني لوقف الحرب على جميع الجبهات
RT STORIES
فانس مدافعا عن استراتيجية واشنطن تجاه إيران: أمريكا رابحة في الحالتين (فيديو)
![فانس مدافعا عن استراتيجية واشنطن تجاه إيران: أمريكا رابحة في الحالتين (فيديو)]() #اسأل_أكثر #Question_More
#اسأل_أكثر #Question_MoreRT STORIES
وسط حراك دبلوماسي متسارع.. مصر وإيران تبحثان فرص التوصل إلى اتفاق نهائي
![وسط حراك دبلوماسي متسارع.. مصر وإيران تبحثان فرص التوصل إلى اتفاق نهائي]() #اسأل_أكثر #Question_More
#اسأل_أكثر #Question_MoreRT STORIES
"فورين بوليسي" تكشف ماذا كسبت واشنطن من "عملية الغضب الملحمي" ضد إيران وماذا خسرت؟
!["فورين بوليسي" تكشف ماذا كسبت واشنطن من "عملية الغضب الملحمي" ضد إيران وماذا خسرت؟]() #اسأل_أكثر #Question_More
#اسأل_أكثر #Question_MoreRT STORIES
هيئة أمريكية: توسيع طريق بحري قبالة سواحل عمان لتسهيل عبور هرمز
![هيئة أمريكية: توسيع طريق بحري قبالة سواحل عمان لتسهيل عبور هرمز]() #اسأل_أكثر #Question_More
#اسأل_أكثر #Question_MoreRT STORIES
إيران تعلن استئناف تسيير الرحلات الجوية المباشرة إلى دبي
![إيران تعلن استئناف تسيير الرحلات الجوية المباشرة إلى دبي]() #اسأل_أكثر #Question_More
#اسأل_أكثر #Question_MoreRT STORIES
مسؤول إيراني يعلن استئناف المبادلات التجارية مع الإمارات
![مسؤول إيراني يعلن استئناف المبادلات التجارية مع الإمارات]() #اسأل_أكثر #Question_More
#اسأل_أكثر #Question_MoreRT STORIES
شهباز شريف: الوضع الإقليمي أثبت أهمية أمن الملاحة البحرية للاقتصاد العالمي وسلاسل الإمداد
![شهباز شريف: الوضع الإقليمي أثبت أهمية أمن الملاحة البحرية للاقتصاد العالمي وسلاسل الإمداد]() #اسأل_أكثر #Question_More
#اسأل_أكثر #Question_MoreRT STORIES
الخارجية الإيرانية الضربات الأمريكية الأخيرة انتهاك صريح لمذكرة التفاهم
![الخارجية الإيرانية الضربات الأمريكية الأخيرة انتهاك صريح لمذكرة التفاهم]() #اسأل_أكثر #Question_More
#اسأل_أكثر #Question_MoreRT STORIES
الجيش الأمريكي ينشر فيديو للضربات الأخيرة لإيران
![الجيش الأمريكي ينشر فيديو للضربات الأخيرة لإيران]() #اسأل_أكثر #Question_More
#اسأل_أكثر #Question_More![اتفاق أمريكي إيراني لوقف الحرب على جميع الجبهات]() اتفاق أمريكي إيراني لوقف الحرب على جميع الجبهات
اتفاق أمريكي إيراني لوقف الحرب على جميع الجبهات
-
![زلزال فنزويلا]()
زلزال فنزويلا
RT STORIES
ارتفاع حصيلة ضحايا زلزال فنزويلا إلى 1430 قتيلا
![ارتفاع حصيلة ضحايا زلزال فنزويلا إلى 1430 قتيلا]() #اسأل_أكثر #Question_More
#اسأل_أكثر #Question_MoreRT STORIES
سوريا ترسل فريق إنقاذ إلى فنزويلا للمشاركة في جهود إزالة آثار الزلزال
![سوريا ترسل فريق إنقاذ إلى فنزويلا للمشاركة في جهود إزالة آثار الزلزال]() #اسأل_أكثر #Question_More
#اسأل_أكثر #Question_More![زلزال فنزويلا]() زلزال فنزويلا
زلزال فنزويلا
-
![العملية العسكرية الروسية في أوكرانيا]()
العملية العسكرية الروسية في أوكرانيا
RT STORIES
الجيش الروسي يستهدف بمسيرات جوية مصفاة نفط قرب زابوروجيه
![الجيش الروسي يستهدف بمسيرات جوية مصفاة نفط قرب زابوروجيه]() #اسأل_أكثر #Question_More
#اسأل_أكثر #Question_MoreRT STORIES
"جزار يراهن على القتلى".. القائد العام لقوات كييف يدفع بجنوده إلى المجهول لإنقاذ استراتيجيته
!["جزار يراهن على القتلى".. القائد العام لقوات كييف يدفع بجنوده إلى المجهول لإنقاذ استراتيجيته]() #اسأل_أكثر #Question_More
#اسأل_أكثر #Question_MoreRT STORIES
فيتسو: سلوفاكيا لن تدعم خلال قمة الناتو تمويل الصراع في أوكرانيا
![فيتسو: سلوفاكيا لن تدعم خلال قمة الناتو تمويل الصراع في أوكرانيا]() #اسأل_أكثر #Question_More
#اسأل_أكثر #Question_MoreRT STORIES
صحيفة: زيلينسكي يستخدم تكتيكات الرايخ الثالث ضد بيلاروس
![صحيفة: زيلينسكي يستخدم تكتيكات الرايخ الثالث ضد بيلاروس]() #اسأل_أكثر #Question_More
#اسأل_أكثر #Question_MoreRT STORIES
الدفاع الروسية تعلن تدمير مقاتلتين أوكرانيتين في مطارهما (فيديو)
![الدفاع الروسية تعلن تدمير مقاتلتين أوكرانيتين في مطارهما (فيديو)]() #اسأل_أكثر #Question_More
#اسأل_أكثر #Question_MoreRT STORIES
الدفاع الروسية: تحرير بلدة جديدة بمقاطعة دنيبروبيتروفسك شرق أوكرانيا
![الدفاع الروسية: تحرير بلدة جديدة بمقاطعة دنيبروبيتروفسك شرق أوكرانيا]() #اسأل_أكثر #Question_More
#اسأل_أكثر #Question_MoreRT STORIES
دونيتسك.. مسيرات FPV الروسية تدمر موقعا للقوات الأوكرانية
#اسأل_أكثر #Question_MoreRT STORIES
إعادة 7 مدنيين روس احتجزتهم قوات كييف في مقاطعة كورسك
![إعادة 7 مدنيين روس احتجزتهم قوات كييف في مقاطعة كورسك]() #اسأل_أكثر #Question_More
#اسأل_أكثر #Question_MoreRT STORIES
الدفاع الروسية: إسقاط 175 مسيرة أوكرانية غربي البلاد
![الدفاع الروسية: إسقاط 175 مسيرة أوكرانية غربي البلاد]() #اسأل_أكثر #Question_More
#اسأل_أكثر #Question_MoreRT STORIES
10 إصابات وتضرر منشأة صناعية بهجوم أوكراني على فولغوغراد الروسية
![10 إصابات وتضرر منشأة صناعية بهجوم أوكراني على فولغوغراد الروسية]() #اسأل_أكثر #Question_More
#اسأل_أكثر #Question_MoreRT STORIES
توقعات بارتفاع الدين العام الأوكراني إلى 330 مليار دولار
![توقعات بارتفاع الدين العام الأوكراني إلى 330 مليار دولار]() #اسأل_أكثر #Question_More
#اسأل_أكثر #Question_MoreRT STORIES
مقتل شخصين وإصابة أربعة في هجمات أوكرانية على جمهورية لوغانسك الشعبية
![مقتل شخصين وإصابة أربعة في هجمات أوكرانية على جمهورية لوغانسك الشعبية]() #اسأل_أكثر #Question_More
#اسأل_أكثر #Question_More![العملية العسكرية الروسية في أوكرانيا]() العملية العسكرية الروسية في أوكرانيا
العملية العسكرية الروسية في أوكرانيا
-
فيديوهات
RT STORIES
روسيا.. طفل صيني يتألق في نهائيات بطولة رقص الصالات
#اسأل_أكثر #Question_MoreRT STORIES
فنزويلا.. مشاهد مروعة لانهيار الأبراج السكنية
#اسأل_أكثر #Question_Moreفيديوهات
الحل الأمثل لإنهاء أزمة الأنسولين حول العالم!
تمكّن فريق من العلماء من إنتاج البروتينات اللازمة للأنسولين البشري في حليب بقرة معدلة وراثيا، ما قد يكون الحل الأمثل لمشاكل إمدادات الأنسولين في العالم.

ويعتقد العلماء أن طريقتهم الجديدة قد تتفوق على طرق إنتاج الأنسولين الحالية، التي تعتمد على الخميرة والبكتيريا المعدلة وراثيا.
واكتشف الأنسولين لأول مرة في عام 1921، وعولج مرضى السكري لسنوات عديدة بالأنسولين المستخرج من بنكرياس الأبقار والخنازير.
ولكن في عام 1978، تم إنتاج أول أنسولين "بشري" باستخدام بروتينات من بكتيريا الإشريكية القولونية المعدلة وراثيا، والتي تعد المصدر الرئيسي للأنسولين الطبي حتى يومنا هذا، إلى جانب العمليات المماثلة التي تستخدم الخميرة بدلا من البكتيريا.
وأدخل فريق البحث، بقيادة عالم الحيوان مات ويلر من جامعة إلينوي "أوربانا شامين"، جزءا معينا من الحمض النووي البشري الذي يرمز للبرونسولين (بروتين يتحول إلى أنسولين) في نواة الخلية لعشرة أجنة بقرة، والتي يتم بعد ذلك زرعها في أرحام الأبقار العادية.
وتطور واحد فقط من الأجنة المعدلة وراثيا إلى حمل أدى إلى ولادة طبيعية لبقرة حية معدلة وراثيا. وعند مرحلة النضج، أجرى الفريق محاولات عدة لجعل البقرة المعدلة وراثيا حاملا، عن طريق التلقيح الاصطناعي والتخصيب في المختبر. ولم تكن أي منها ناجحة، لكن الفريق لاحظ أن هذا قد يكون متعلقا بكيفية تكوين الجنين أكثر من حقيقة أنه تم تعديله وراثيا.
"وجبات عفنة" يقدمها العلماء لإنقاذ كوكبنا
ولكنهم تمكنوا من جعل البقرة تدر الحليب عن طريق الحث الهرموني، وذلك باستخدام طريقة غير معلنة منسوبة إلى خبير تكنولوجيا تكاثر الحيوان، بيترو باروسيلي، من جامعة ساو باولو.
وتم فحص كمية الحليب القليلة التي أنتجتها البقرة على مدار شهر للبحث عن بروتينات معينة، وكُشف عن شريطين لهما كتل جزيئية مماثلة للبرونسولين والأنسولين البشري، والتي لم تكن موجودة في حليب الأبقار غير المعدلة وراثيا.
كما كشف العلماء عن وجود الببتيد C الذي أزيل من البرونسولين البشري في عملية تكوين الأنسولين، ما يشير إلى أن الإنزيمات الموجودة في حليب البقر ربما تكون قد حولت البرونسولين "البشري" إلى أنسولين.
وقال ويلر إنه إذا أنتجت كل بقرة غراما واحدا من الأنسولين لكل لتر من الحليب، فهذا يعني 28818 وحدة من الأنسولين.
وأضاف: "أستطيع أن أرى مستقبلا حيث يمكن لقطيع مكون من 100 رأس بقرة أن ينتج كل الأنسولين الذي تحتاجه البلاد. ومع قطيع أكبر يمكنك توفير إمدادات العالم كله في عام واحد".
نشرت الدراسة في مجلة التكنولوجيا الحيوية.
المصدر: ساينس ألرت
إقرأ المزيد

أنظمة الأنسولين الآلي تثبت فعاليتها في إدارة السكري لكبار السن
أظهرت دراسة جديدة، أجرتها جامعة ولاية واشنطن، أن أنظمة توصيل الأنسولين الآلي (AID) تعد آمنة وفعالة للاستخدام من قبل كبار السن المصابين بداء السكري من النوع الأول.








































































































































































التعليقات